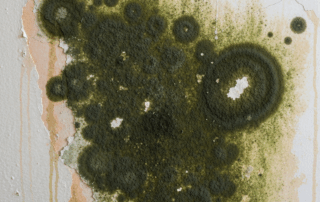
Indoor Mold

Mastering Compliance: A Deep Dive into NC Asbestos Rules, Regulations & Ordinances with Piedmont Quality Air
Mastering Compliance: Why Understanding NC Asbestos Rules is CrucialUnderstanding the complex landscape of NC Asbestos Rules, Regulations & Ordinances is critical for homeowners, property managers, and contractors across North Carolina. Asbestos, a naturally occurring mineral fiber, was once widely used in construction due to its remarkable resistance to heat, fire, and insulating [...]
Piedmont Quality Air’s Essential Mold Prevention & Remediation Guide for Charlotte Homes
Understanding Mold: A Vital Guide for Charlotte HomeownersFor homeowners in Charlotte, North Carolina, understanding the nuances of mold growth and its impact is crucial. The region's warm, humid climate creates an ideal environment for mold to thrive, making effective Mold Prevention & Remediation Guide an essential tool for maintaining healthy and safe [...]
DIY Demolition Disasters: Understanding the Critical DIY home demolition risks
The Appeal of DIY Demolition: A Cost-Saving Illusion?Many homeowners are drawn to the idea of do-it-yourself (DIY) demolition, envisioning significant cost savings and the satisfaction of personal involvement in home renovation. However, the initial allure of a bargain can quickly turn into a costly and dangerous undertaking when not approached with professional [...]
Beyond the Spores: Uncovering the Hidden Health Risks of Home Mold
Beyond the Visible: Understanding the Invisible Threat of Home MoldMold is a ubiquitous and often unseen intruder in countless homes, silently posing a threat that extends far beyond mere aesthetics. While many homeowners associate mold with unsightly stains and unpleasant, musty odors, the true danger lies in the hidden health risks of [...]
Charlotte Mold Removal: Piedmont Quality Air’s Expert Solutions for Healthier Living
Safeguarding Your Space: The Importance of Mold Removal in CharlotteMold is a pervasive issue that can compromise the safety and integrity of homes and businesses. Effective Charlotte mold removal is not merely about aesthetics; it's a critical process for ensuring healthy living environments. Unaddressed mold can lead to significant health problems for [...]
Unlock Your Remodel: Expert Charlotte NC Home Interior Renovation Demolition by Piedmont Quality Air
Unlock Your Dream Remodel: The Essential First Step in Charlotte, NCEmbarking on a home renovation project in Charlotte, NC, is an exciting journey toward transforming your living space. Whether you're dreaming of an open-concept kitchen, a luxurious master bathroom, or a complete interior overhaul, the critical first step often involves precise Charlotte [...]
Your Essential Guide to Asbestos and Mold for Renters and Homeowners: Risks, Rights, and Remediation
Protecting Your Living Space from Hidden HazardsLiving in a home or apartment should bring comfort, not hidden threats. For many, the silent dangers of Asbestos and Mold for Renters and Homeowners can undermine safety. These pervasive contaminants often go unnoticed until health issues arise or significant property damage occurs. Understanding the risks, [...]
Your Trusted Partner for Safe Asbestos Removal in Charlotte, NC with Piedmont Quality Air
Is Your Charlotte, NC Property Safe? Understanding Asbestos RisksFor many property owners in Charlotte, NC, the question of asbestos safety is a critical concern. Asbestos, a naturally occurring fibrous mineral, was once widely celebrated for its remarkable resistance to heat, fire, and corrosion. These desirable properties led to its widespread use in [...]
Piedmont Quality Air: Secure Your Home with Free Asbestos Removal Estimates Charlotte NC
Is Your Charlotte Home Hiding a Silent Threat? Understanding AsbestosMany homes in Charlotte, NC, particularly those built before the 1980s, may harbor a hidden danger: asbestos. This naturally occurring mineral fiber was once celebrated for its exceptional heat resistance, durability, and insulating properties, leading to its widespread use in thousands of building [...]
Commercial Interior Demolition: Your Essential Guide to Modern Space Transformation
Unlocking Modern Spaces: The Power of Commercial Interior DemolitionTransforming commercial properties often begins with a critical first step: Commercial Interior Demolition. Unlike full structural demolition, which brings down an entire building, interior demolition focuses on meticulously removing internal structures while preserving the exterior and structural integrity. This process is essential for revitalizing [...]
Trusted Experts for Safe Asbestos Removal in Charlotte, NC | Piedmont Quality Air
Facing Asbestos Dangers in Your Charlotte PropertyAsbestos, a naturally occurring fibrous mineral, was once lauded for its resistance to heat, fire, and corrosion. This made it a popular component in over 3,000 building materials until the mid-1980s, meaning many older homes and commercial properties in Charlotte, NC, likely contain it. While undisturbed [...]
Trusted Experts for Safe Asbestos Removal in Charlotte, NC | Piedmont Quality Air
Facing Asbestos Dangers in Your Charlotte PropertyAsbestos, a naturally occurring fibrous mineral, was once lauded for its resistance to heat, fire, and corrosion. This made it a popular component in over 3,000 building materials until the mid-1980s, meaning many older homes and commercial properties in Charlotte, NC, likely contain it. While undisturbed [...]
Indoor Air Quality Testing Charlotte NC: Breathe Easier with Piedmont Quality Air
Breathing Easy in the Queen City: Why Indoor Air Quality Matters for Charlotte ResidentsFor residents of Charlotte, NC, conversations about air quality often focus on outdoor conditions, with reports from organizations like the American Lung Association highlighting regional challenges with ozone and particle pollution. While outdoor air quality is undeniably important, what [...]
Expert Commercial Interior Demolition Charlotte NC: Preparing Your Space with Precision
Expert Commercial Interior Demolition in Charlotte NC: Transforming Your SpaceTransforming a commercial space in Charlotte often begins with strategic interior demolition. Whether it's to prepare for a major renovation, reconfigure an office layout, or completely gut a retail unit, precise commercial interior demolition Charlotte NC is the foundational step. This process involves [...]
Breathing Easier: The Profound Health Benefits of Mold Remediation for Your Home and Family
Breathing Easier: Unveiling the Importance of Indoor Air QualityMaintaining optimal indoor air quality is paramount for the health and well-being of your family. Poor indoor air quality, often exacerbated by hidden hazards like mold, can significantly impact respiratory health and overall comfort. Understanding the fundamental role of clean air in your home [...]
What is Indoor Air Quality? A Comprehensive Guide from Piedmont Quality Air
The Hidden World Within: Understanding Your Indoor Air EnvironmentMany of us tend to think of air pollution as a concern primarily outside our homes and workplaces. However, the air within our buildings, where we spend an estimated 90% of our time, plays a crucial role in our overall well-being. Understanding what is [...]
Understanding Crawl Space Mold Dangers and Professional Removal NC by Piedmont Quality Air
The Silent Threat Beneath Your North Carolina Home: Understanding Crawl Space MoldNorth Carolina's humid climate, while beautiful, creates an ideal environment for a hidden menace beneath many homes: crawl space mold. This insidious growth can silently undermine your property's structural integrity and pose significant health risks to its occupants. Addressing these crawl [...]
Piedmont Quality Air: Your Expert Partner for Demolition, Asbestos, Mold and Lead Removal SC
Protecting Your Investment: Why Professional Demolition and Hazard Removal Matters in SCEmbarking on any demolition project in South Carolina, whether for a cherished family home or a vast commercial structure, involves far more than just knocking down walls. It necessitates a critical understanding of what lies beneath the surface: hidden hazardous materials. [...]
Beyond Asbestos: Comprehensive Hazardous Materials Removal Charlotte NC by Piedmont Quality Air
Beyond Asbestos: Unveiling Hidden Hazards in Charlotte NC PropertiesWhile asbestos often takes center stage in discussions about dangerous building materials, properties in Charlotte, NC, can harbor a broader spectrum of unseen threats requiring professional Hazardous Materials Removal Charlotte NC. From aging infrastructure to everyday chemicals improperly stored, these hidden hazards pose significant [...]
Piedmont Quality Air Charlotte NC Environmental Abatement Demolition: Your Partner for a Safer, Healthier Space
Understanding Environmental Challenges in Charlotte, NCCharlotte, North Carolina, a city characterized by its dynamic growth and vibrant community, faces a complex array of environmental challenges. Rapid urbanization often introduces concerns such as air pollution, compromised water quality, and the reduction of vital green spaces. Addressing these issues is crucial for maintaining the [...]
Seamless Renovations Start Here: Professional Interior Demolition Charlotte by Piedmont Quality Air
Seamless Renovations Start Here: The Role of Professional Interior DemolitionTransforming a space, whether it's a home or a commercial establishment, often begins with a critical first step: interior demolition. This process involves the careful and strategic removal of internal structures, walls, fixtures, and finishes to prepare a property for renovation, remodeling, or [...]
Advanced Strategies for Unrivaled Industrial Demolition Efficiency and Safety
Introduction: The Critical Role of Industrial Demolition in Modern DevelopmentIndustrial demolition plays a pivotal role in the continuous evolution of urban and industrial landscapes. It's a specialized field that addresses the complex challenges of removing large-scale facilities, often laden with heavy machinery, intricate systems, and potentially hazardous materials. Achieving advanced industrial demolition [...]
Piedmont Quality Air: Comprehensive Asbestos Abatement, Mold Remediation & Removal for a Safer Home & Business
Protecting Your Indoor Environment with Piedmont Quality AirIn North and South Carolina, maintaining a safe and healthy indoor environment is paramount for both homes and businesses. Hidden dangers like asbestos and mold can severely impact air quality and pose significant health risks. At Piedmont Quality Air, we specialize in comprehensive Asbestos Abatement, [...]
Achieve a Healthier Home with Piedmont Quality Air: Comprehensive Asbestos Abatement, Mold Remediation & Removal
Introduction: Securing a Healthier Indoor Environment with Piedmont Quality AirCreating and maintaining a healthy indoor environment is paramount for the well-being of families and employees alike. However, homes and commercial properties, particularly older structures, can harbor unseen dangers such as asbestos and mold. These pervasive contaminants necessitate specialized interventions. At Piedmont Quality [...]
Mastering Asbestos Hazard Management in North Carolina: A Piedmont Quality Air Guide to Safety & Compliance
Understanding Asbestos: A Silent Threat in North Carolina PropertiesAsbestos, a naturally occurring group of fibrous minerals, once held widespread appeal in construction throughout North Carolina due to its exceptional resistance to heat, fire, and corrosion. Utilized in over 3,000 different building materials until the late 20th century, its presence remains a silent [...]
Ensuring Absolute Safety: The Critical Role of Air Monitoring During Asbestos Removal Projects
Ensuring Absolute Safety: Why Air Monitoring is Non-Negotiable During Asbestos RemovalWhen undertaking asbestos removal projects, the invisible nature of asbestos fibers makes stringent safety measures absolutely critical. One of the most vital components of these safety protocols is comprehensive Air Monitoring During Asbestos Removal Projects. This process isn't merely a regulatory formality; [...]
Piedmont Quality Air: Your Trusted Experts for Asbestos Abatement, Mold Remediation & Removal
Introduction: Protecting Your Indoor Environment with Piedmont Quality AirMaintaining a healthy and safe indoor environment is paramount for homeowners and businesses alike. Invisible threats such as asbestos and mold can severely compromise air quality and pose significant health risks. Addressing these concerns effectively requires specialized knowledge and meticulous execution. This is where [...]
The Ultimate Piedmont NC Mold Prevention Guide: Keep Your Home Healthy with Piedmont Quality Air
Introduction: Protecting Your Piedmont NC Home from MoldMaintaining a healthy home environment is a top priority for homeowners in Piedmont, NC. However, one silent threat often undermines these efforts: mold. Mold is not just an unsightly nuisance; it can pose significant health risks and cause extensive property damage if left unaddressed. This [...]
Ensuring Safety & Compliance: Your Guide to Asbestos Hazard Management in North Carolina with Piedmont Quality Air
Understanding the Hidden Dangers: Asbestos in North Carolina PropertiesAsbestos, a naturally occurring fibrous mineral, was once highly valued for its heat resistance, durability, and insulating properties. This led to its widespread use in over 3,000 different building materials across North Carolina and the nation, especially in structures built before the 1980s. Understanding [...]
Professional Residential Mold Removal Charlotte NC by Piedmont Quality Air
The Hidden Threat: Understanding Mold in Your Charlotte NC HomeMold is more than just an unsightly stain; it represents a significant, often hidden, threat to the health and structural integrity of your home in Charlotte, NC. This pervasive fungus thrives in damp, warm environments, releasing microscopic spores into the air. While mold [...]
Piedmont Quality Air Charlotte NC Environmental Abatement Demolition: Your Trusted Partner for a Healthier Space
Navigating Environmental Challenges in Charlotte, NC: An OverviewCharlotte, North Carolina, a city celebrated for its dynamic growth and vibrant community, also confronts a complex array of environmental challenges. Rapid urbanization often brings with it concerns such as air pollution, compromised water quality, and the diminishing of vital green spaces. These issues are [...]
Expert Solutions for a Healthy Home: Piedmont Quality Air Charlotte NC Mold Damage Repair
Understanding Mold Damage: A Threat to Charlotte, NC Homes and BusinessesMold growth is a pervasive issue that can significantly impact properties throughout Charlotte, NC, posing both structural and health risks. When excessive moisture infiltrates and accumulates in a property, particularly if left unaddressed, mold can thrive on organic materials like drywall, wood, [...]
Navigating Risks: A Piedmont Quality Air Guide to Hazardous Materials in Old Buildings
Uncovering the Dangers: Navigating Hazardous Materials in Old BuildingsOlder buildings possess a unique charm and historical significance, but they often conceal invisible dangers within their very fabric. As structures age, the materials used in their original construction, once considered innovative, can degrade and become significant health hazards. Understanding and addressing these hazardous [...]
Piedmont Quality Air’s Guide to the Asbestos NESHAP Program and Regulations
Understanding the Asbestos Threat and the Importance of NESHAPAsbestos, a naturally occurring fibrous mineral, was once lauded for its fire-resistant and insulating properties, leading to its widespread use in construction materials until the late 20th century. However, the disturbance of asbestos-containing materials (ACMs) releases microscopic fibers into the air, posing severe health [...]
Piedmont Quality Air: The Trusted Choice for Interior Commercial Demolition Services NC & SC
Transforming Commercial Spaces: The Demand for Modernization in NC & SCThe dynamic business landscape across North Carolina and South Carolina constantly drives the need for commercial spaces to evolve. From revitalizing outdated offices to reconfiguring retail layouts, businesses are actively seeking ways to modernize their environments to enhance functionality, aesthetics, and employee [...]
Piedmont Quality Air: Expert Commercial Interior Demo Services for Seamless Renovations
Introduction: Transforming Commercial Spaces with Expert Interior DemolitionIn the dynamic world of commercial real estate, businesses often seek to revitalize their spaces to meet evolving needs, enhance aesthetics, or improve functionality. This transformation frequently begins with precise and professional Commercial Interior Demo Services. Unlike structural demolition, which aims to bring down an [...]
Hidden Hazards: Why a Mold Inspection Before Renovation is Crucial for a Safe Remodel by Piedmont Quality Air
Hidden Hazards: Uncovering Mold Before Your North Carolina RemodelEmbarking on a home renovation project in North Carolina is an exciting prospect, promising new aesthetics and improved functionality. However, it's crucial to acknowledge the potential for hidden issues, especially when dealing with older homes or areas prone to moisture. One such silent threat [...]
Expert Mold Cleanup in Your Home: When to Call Piedmont Quality Air
Understanding the Silent Threat: Mold in Your HomeMold is a ubiquitous fungus that thrives in damp environments, a silent invader capable of compromising both the structural integrity of your property and the health of its occupants. Understanding what mold is and how it establishes itself is the first crucial step in effective [...]
Safeguard Your Renovation: Why Abatement Before Renovation is Non-Negotiable in NC & SC
Renovation Dreams and Hidden Dangers: Why Abatement is Critical in NC & SCEmbarking on a renovation project in North or South Carolina is an exciting prospect, promising to transform your property into a dream space. However, beneath the surface of older homes and commercial buildings often lie hidden hazards that can turn [...]
Your Guide to a Cleaner Home: Essential Small Mold Area Cleanup Tips
The Hidden Threat: Why Small Mold Needs Immediate AttentionEven a small patch of mold in your home can signal a larger, unseen issue and poses potential risks to both your property and health. Mold, a type of fungus, thrives in damp environments and reproduces through microscopic spores that are naturally present in [...]
Piedmont Quality Air: Expert Asbestos Removal in Charlotte, NC
Piedmont Quality Air: Your Trusted Partner for Asbestos Safety in Charlotte, NCEnsuring the safety of your home or business environment is paramount, especially when facing hazardous materials like asbestos. Piedmont Quality Air stands as your dedicated expert for Asbestos Removal in Charlotte, NC. With a steadfast commitment to health, safety, and strict [...]
Trust the Pros for Removing Asbestos Salisbury NC & Gastonia NC | Piedmont Quality Air
Understanding the Hidden Danger Asbestos in Your North Carolina PropertyAsbestos, a naturally occurring mineral once lauded for its remarkable resistance to heat, fire, and corrosion, was a ubiquitous material in construction throughout much of the 20th century. However, the discovery of its severe health risks has transformed it into a silent threat. [...]
Piedmont Quality Air: Your Trusted Experts for Mold Remediation in Charlotte, NC
Piedmont Quality Air: Your Trusted Experts for a Healthy Home in Charlotte, NCMaintaining a healthy living environment is a top priority for homeowners in Charlotte, NC. One of the most common and persistent challenges many face is mold growth. When ignored, mold can not only compromise your property's structural integrity but also [...]
Piedmont Quality Air: Advanced Environmental Remediation Air Quality Systems for a Healthier North Carolina
Piedmont Quality Air: Building Healthier Indoor Environments Across North CarolinaIn North Carolina, maintaining optimal indoor air quality is paramount for both residential and commercial properties. Factors ranging from natural disasters to aging infrastructure can introduce hazardous contaminants into our living and working spaces. This is where the critical role of Environmental Remediation [...]
Piedmont Quality Air: Your Local Experts for Asbestos Removal in Charlotte, NC
Protecting Your Charlotte, NC Property: The Critical Need for Asbestos RemovalEnsuring the safety and well-being of your property in Charlotte, NC, means understanding and addressing potential hazards like asbestos. Asbestos, a naturally occurring mineral once prized for its heat resistance and insulating properties, is now recognized as a severe health risk. When [...]
Safe & Professional Removing Asbestos Salisbury NC & Gastonia NC by Piedmont Quality Air
The Hidden Danger: Why Professional Asbestos Removal is Crucial for Salisbury NC & Gastonia NCAsbestos, a naturally occurring fibrous mineral, was once lauded for its remarkable resistance to heat, fire, and corrosion, making it a ubiquitous material in construction throughout much of the 20th century. However, the discovery of its severe health [...]
Piedmont Quality Air: Your Top-Rated Mold Removal Service in Charlotte, NC
Understanding Mold: A Common Concern for Charlotte, NC PropertiesMold is a prevalent issue that can affect properties across Charlotte, NC. This pervasive fungus thrives in damp environments, appearing as fuzzy growths in various colors like gray, black, green, or yellow. Molds are a natural part of our outdoor environment, releasing tiny spores [...]
5 Warning Signs You Need Mold Remediation in Charlotte – Piedmont Quality Air
The Sneaky Threat of Mold in Your Charlotte HomeMold is a silent intruder that can wreak havoc on your property and health. Thriving in damp, warm environments, it can quickly establish itself in homes across Charlotte, often going unnoticed until it becomes a significant problem. Addressing mold promptly is crucial for maintaining [...]
Seamless Transformations: The Power of Interior Demolition in Commercial Renovations
Unlocking Potential: The Impact of Interior Demolition in Commercial SpacesIn the dynamic world of commercial real estate, achieving a fresh, modern aesthetic or a completely reimagined layout often begins with a crucial first step: interior demolition in commercial renovations. This isn't merely about tearing down walls; it's a strategic process that unlocks [...]
Mastering Building Safety: How to Conduct a Hazardous Materials Assessment in Buildings with Piedmont Quality Air
Mastering Building Safety: The Importance of Hazardous Materials AssessmentsEnsuring the safety and longevity of any building, especially older structures, begins long before any renovation or demolition work commences. A critical, often underestimated, step in this process is conducting a comprehensive hazardous materials assessment. This proactive approach is essential for identifying and mitigating [...]
Achieve Peace of Mind: Asbestos Hazard Management in North Carolina with Piedmont Quality Air
Achieving Peace of Mind: Understanding Asbestos in Your North Carolina PropertyAsbestos, a naturally occurring mineral once lauded for its heat resistance and insulating properties, is now recognized as a severe health hazard. For property owners across North Carolina, understanding the risks associated with this fibrous material is the first step toward effective [...]
Piedmont Quality Air: Expert Mold Remediation in Charlotte, NC for a Healthy Home
Piedmont Quality Air: Protecting Your Charlotte, NC Home from MoldIn Charlotte, NC, maintaining a healthy home environment is paramount, and addressing issues like mold growth is a critical component of home care. Mold not only detracts from your property's aesthetics but can also pose significant health risks to its occupants. Expert mold [...]
Expert Asbestos Removal in Charlotte, NC: Your Safety with Piedmont Quality Air
Understanding Asbestos Risks in Your Charlotte, NC PropertyFor homeowners and businesses in Charlotte, NC, understanding the potential risks associated with asbestos is paramount. Asbestos, a naturally occurring fibrous mineral, was once widely celebrated for its insulating, fire-resistant, and strengthening properties. Consequently, it found its way into countless building materials across the United [...]
Raleigh Office Air Quality Testing: Protect Employee Health & Boost Productivity with Piedmont Quality Air
Why Indoor Air Quality is Crucial for Raleigh OfficesMaintaining excellent indoor air quality (IAQ) is paramount for businesses in Raleigh, particularly when it comes to the well-being and productivity of employees. Poor IAQ can lead to a range of adverse health effects, including headaches, fatigue, respiratory issues, and allergic reactions, which directly [...]
Protect Your NC Home & Health: Navigating Asbestos During Home Renovation North Carolina
Your North Carolina Home Renovation Project: Understanding Hidden DangersEmbarking on a home renovation project in North Carolina is an exciting endeavor, promising refreshed spaces and increased property value. However, for homes built before the 1980s, a hidden danger can lurk within the walls, ceilings, and flooring: asbestos. Understanding the risks associated with [...]
Seamless Industrial Revitalization: Choose Piedmont Quality Air, Charlotte NC Factory Interior Demolition Experts
Revitalizing Charlotte Industry: The Strategic Edge of Interior DemolitionIn Charlotte, NC's dynamic industrial landscape, change is constant. Obsolete factory layouts often hinder modern operational efficiency, demanding strategic renovation rather than outright demolition. This is where interior demolition plays a pivotal role, offering a precise pathway to industrial revitalization. It's not merely about [...]
Breathe Easy: The Crucial Role of Asbestos and Mold Air Sampling and Clearance Testing with Piedmont Quality Air
Unmasking Invisible Threats: Why Indoor Air Quality Matters in North CarolinaIn North Carolina, the comfort of our indoor spaces often belies potential dangers. We spend a significant portion of our lives within homes and workplaces, making the quality of that indoor air paramount. Hidden threats like asbestos and mold can silently compromise [...]
Transforming Spaces, Ensuring Safety: Piedmont Quality Air Charlotte NC Environmental Abatement Demolition
Navigating Environmental Challenges in a Growing City like Charlotte, NCCharlotte, North Carolina, a city celebrated for its dynamic growth and vibrant community, also confronts a complex array of environmental challenges. Rapid urbanization often brings with it concerns such as air pollution, compromised water quality, and the diminishing of vital green spaces. These [...]
Piedmont Quality Air: Essential Strategies for Health Protection During Occupied Building Renovations
Introduction to Health Protection During Occupied Building RenovationsUndertaking renovations in occupied buildings presents unique challenges, particularly when it comes to safeguarding the health of occupants and workers. The delicate balance between improving a space and maintaining a safe indoor environment requires meticulous planning and stringent adherence to safety protocols. Ensuring health protection [...]
Piedmont Quality Air: Your Professional Guide to Safely Handling & Disposing Asbestos
Piedmont Quality Air: Your Professional Guide to Safely Handling & Disposing AsbestosAsbestos, a once-lauded mineral fiber, saw widespread use in construction throughout North Carolina properties due to its exceptional resistance to heat and corrosion. However, its microscopic fibers, when disturbed, pose severe health risks, including debilitating lung diseases and various cancers. The [...]
Piedmont Quality Air Charlotte NC Environmental Abatement Demolition: Your Trusted Local Experts
Navigating Environmental Challenges in Charlotte, NC: An IntroductionCharlotte, North Carolina, a city renowned for its rapid growth and vibrant atmosphere, also faces significant environmental challenges. These issues, ranging from air and water pollution to the loss of vital green spaces, are deeply intertwined with urban development and often disproportionately affect vulnerable communities. [...]
The Strategic Edge: How Expert Commercial Interior Demolition Fuels Your Renovation Success
The Strategic Edge: Unlocking Renovation Success with Expert Commercial Interior DemolitionEmbarking on a commercial renovation project often requires a foundational step that is frequently underestimated: professional commercial interior demolition. This crucial initial phase involves the careful and strategic removal of non-structural elements within a building, setting the stage for successful modernization, redesign, [...]
Trusted & Thorough: Your Guide to Piedmont Quality Air Charlotte NC Mold Damage Repair
Understanding Mold Damage: A Threat to Charlotte, NC Homes and BusinessesMold is a persistent and often unseen adversary for property owners in Charlotte, NC. Thriving in damp, warm environments, it can rapidly colonize homes and businesses, leading to significant structural damage and potential health concerns. The presence of mold indicates an underlying [...]
Piedmont Quality Air: Your Partner for Effective Commercial Mold Prevention Charlotte NC
Understanding the Threat: Commercial Mold in Charlotte, NCCommercial properties in Charlotte, NC, face a unique set of challenges, and among the most insidious is the threat of mold. More than just an unsightly nuisance, mold in a business environment can lead to significant problems for both the building and its occupants. Mold, [...]
Piedmont Quality Air: Expert Services for Removing Asbestos Salisbury NC & Gastonia NC
Understanding the Dangers of Asbestos in Your Salisbury NC & Gastonia NC PropertyAsbestos, a naturally occurring fibrous mineral, was once hailed for its remarkable heat resistance and durability. Consequently, it was widely incorporated into thousands of building materials until the late 1970s. For property owners and residents in North Carolina, especially those [...]
Piedmont Quality Air: Why Trust Our Mold Remediation Professionals for a Safer Home
The Silent Invader: Understanding Mold in Your Home and Its DangersMold, a ubiquitous type of fungus, is a silent invader that can significantly compromise the health and structural integrity of your home. These microscopic organisms are naturally present in the environment, both indoors and outdoors, but become problematic when they find ideal [...]
Piedmont Quality Air’s Guide to Remediation, Restoration, Natural Resource Damage Assessment: Building a Sustainable Future
Navigating Environmental Health: An Introduction to a Sustainable Future for Your North Carolina PropertyEnsuring the long-term health and value of your North Carolina property requires a proactive approach to environmental challenges. From unforeseen contamination to the need for ecological revitalization, understanding the interconnected processes of remediation, restoration, and natural resource damage assessment [...]
Protect Your Health: The Essential Health Benefits of Mold and Asbestos Removal with Piedmont Quality Air
Unseen Dangers: Protecting Your Health from Mold and Asbestos in Your South Carolina HomeWithin many homes and commercial buildings across South Carolina lie hidden environmental hazards: mold and asbestos. These insidious contaminants, often invisible or overlooked, pose significant threats to the well-being of occupants. The humid climate of South Carolina, unfortunately, provides [...]
Piedmont Quality Air: Mastering commercial interior demolition for Modern Spaces
Elevating Commercial Spaces: The Power of Strategic Interior DemolitionModern commercial environments demand flexibility, efficiency, and aesthetics. Achieving these often requires a foundational transformation, a process expertly handled by strategic commercial interior demolition. This isn't merely about removing structures; it's about meticulously preparing a space for its next chapter, ensuring it aligns perfectly [...]
Minimize Disruption: Achieving Safe and Dust-Free Demolition in Occupied Spaces
When renovation or remodeling is required in commercial and industrial settings, the demolition phase presents a critical challenge: achieving precise, selective removal without disrupting ongoing business operations or compromising the health and safety of occupants. For active environments like offices, retail spaces, manufacturing plants, or even healthcare facilities, traditional, messy demolition methods [...]
Piedmont Quality Air: Your Trusted Experts for Removing Asbestos Salisbury NC & Gastonia NC
Understanding the Silent Threat: Asbestos in North Carolina PropertiesAsbestos, a naturally occurring group of minerals composed of tiny, easily inhaled fibers, was once lauded for its exceptional heat resistance, insulating properties, and durability. This made it a common component in over 3,000 different building materials until the late 20th century. Unfortunately, its [...]
Expert Interior Demolition: Seamless Renovation Prep with Piedmont Quality Air
Beyond the Wrecking Ball: Understanding Expert Interior DemolitionModern renovations often begin not with construction, but with careful deconstruction. This precise process, known as Interior Demolition, involves systematically removing non-structural elements within a building to prepare for a new layout or design. Unlike full-scale demolition that levels an entire structure, interior demolition focuses [...]
Piedmont Quality Air: Expert Solutions for Asbestos, Lead and Mold Abatement & Remediation
Piedmont Quality Air: Protecting Your Environment in North CarolinaEnsuring the safety and health of your property in North Carolina is paramount, especially when facing environmental hazards like asbestos, lead, and mold. These silent threats can compromise indoor air quality, pose significant health risks, and diminish property value if left unaddressed. At Piedmont [...]
Piedmont Quality Air: Mold Myths, Facts, and When to Call the Pros for Safe Remediation
Demystifying Mold: Separating Fact from Fiction for a Healthier PropertyMold is a pervasive issue that can impact properties and health, particularly in humid climates like South Carolina. Microscopic mold spores are naturally present everywhere, both indoors and outdoors, but they only become a problem when they find sufficient moisture and a food [...]
Mastering the Hazardous Building Materials Assessment: A Guide to Safety & Compliance with Piedmont Quality Air
Introduction: Mastering Your Property's Safety and ComplianceEnsuring the safety and long-term value of your property begins with understanding its hidden risks. A comprehensive hazardous building materials assessment is not merely a precautionary measure but a critical step toward safeguarding health, ensuring legal compliance, and protecting your investment. North Carolina's diverse architectural landscape [...]
Professional Interior Demolition Charlotte: Prepare Your Space with Piedmont Quality Air
Transforming Your Space: The Power of Professional Interior DemolitionEmbarking on a renovation or remodeling project often begins with a critical first step: clearing out the old to make way for the new. This is where professional interior demolition Charlotte services become invaluable, providing the foundation for a successful transformation. Whether you're planning [...]
Expert Mold Removal Charlotte NC: Trust Piedmont Quality Air
Understanding Mold in Your Charlotte NC Home or BusinessMold is a naturally occurring fungus that can thrive in damp conditions, both outdoors and indoors. While mold spores are ubiquitous in the air, their excessive growth inside your home or business in Charlotte, NC, is an abnormal condition indicating a moisture problem. Mold [...]
Beyond the Mess: Clearing Out Construction Debris with Charlotte Junk Removal Experts for a Smooth Project Finish
Introduction: The Unseen Challenge of Construction Debris in Charlotte, NCCharlotte, North Carolina, is a city experiencing rapid growth and development. Everywhere you look, new construction projects are underway, transforming the urban landscape. While this development signals progress, it also brings a significant, often underestimated, challenge: managing construction and demolition (C&D) debris. From [...]
Protect Your Home: Professional Asbestos Removal in Charlotte, NC by Piedmont Quality Air
Understanding the Hidden Danger: Asbestos in Your Charlotte, NC HomeMany homes in Charlotte, NC, particularly those built before the 1980s, may harbor a silent threat: asbestos. This naturally occurring mineral was once widely celebrated for its remarkable insulating and fire-resistant properties, leading to its widespread use in thousands of building materials. However, [...]
Piedmont Quality Air: Expertise in Demolition, Asbestos, Mold and Lead Removal for Safer SC Properties
Protecting Your Investment: Ensuring a Safe and Healthy South Carolina PropertyMaintaining a safe and healthy property in South Carolina is crucial for both homeowners and business owners. Beyond aesthetic appeal, addressing hidden hazards like asbestos, mold, and lead is paramount. Professional removal of hazardous materials before demolition or renovation is not just [...]
Piedmont Quality Air’s Guide to Mastering Industrial Demolition for Safety and Efficiency
Introduction: Why Industrial Demolition Demands Expertise and Precision The dismantling of industrial structures is a complex undertaking, far removed from standard construction. It requires an unparalleled level of expertise, meticulous planning, and rigorous execution to ensure safety, minimize environmental impact, and achieve operational efficiency. At its core, industrial demolition is a specialized [...]
NC Asbestos Compliance for Homeowners: An Expert Guide from Piedmont Quality Air
Introduction: Protecting Your North Carolina Home from AsbestosEnsuring the safety and well-being of your family begins within the walls of your home. For many North Carolina homeowners, an often-overlooked but critical concern is the presence of asbestos, a hazardous material once common in building construction. Understanding NC asbestos compliance for homeowners is [...]
Expert North Charlotte Mold Damage Services: Restore Your Home’s Health & Safety
Safeguarding Your Home: Understanding Mold Damage in North CharlotteMold is a pervasive and problematic issue that can compromise the structural integrity of your home and pose significant health risks. In North Charlotte, the region's climate, characterized by higher temperatures and humidity, particularly during spring and summer, creates an ideal environment for mold [...]
Protect Your Home & Health: Essential Home Mold Prevention Tips from Piedmont Quality Air
Protect Your Sanctuary: Why Home Mold Prevention MattersYour home is your haven, a place where you and your family should feel safe and healthy. However, a silent intruder—mold—can compromise both the structural integrity of your property and the well-being of its occupants. Understanding and implementing effective home mold prevention tips is crucial [...]
Elevate Your Business Safety with Piedmont Quality Air’s Expert Commercial Environmental Remediation
Safeguarding Your Business: The Imperative of Environmental RemediationIn today's complex commercial landscape, businesses face a myriad of challenges, not least among them the critical need for robust environmental stewardship. Beyond ethical considerations, proactively addressing potential environmental hazards is a fundamental aspect of sustainable business operations. This is where commercial environmental remediation becomes [...]
Your Guide to Safe and Compliant Asbestos Hazard Management in North Carolina with Piedmont Quality Air
Understanding Asbestos in North Carolina: A Critical OverviewUnderstanding the critical landscape of N.C. Asbestos Rules, Regulations & Ordinances is essential for homeowners, property managers, and contractors. Asbestos, a naturally occurring mineral fiber, found widespread use in over 3,000 different building materials due to its exceptional resistance to heat and corrosion. Even today, [...]
Piedmont Quality Air: Your Essential Guide to Expert Asbestos Hazard Management in North Carolina
Understanding Asbestos Hazards in North Carolina PropertiesNorth Carolina, like many states, grapples with the legacy of asbestos—a naturally occurring mineral once widely used in construction due to its heat resistance and insulating properties. However, its microscopic fibers can become airborne when disturbed, posing severe health risks. Effective expert asbestos hazard management in [...]
Piedmont Quality Air: What You Need to Know When Hiring an Asbestos Removal Company
The Critical Need for Professional Asbestos RemovalWhen asbestos-containing materials are identified in your home or business, the decision to address them requires careful consideration, with hiring an asbestos removal company being the safest and most prudent choice. Asbestos, a naturally occurring mineral once prized for its durability and fire resistance, poses severe [...]
Piedmont Quality Air: Comprehensive Asbestos, Mold and Lead Removal for Safer SC Properties
Protecting South Carolina Properties: The Need for Hazardous Material RemovalMaintaining a safe and healthy property in South Carolina is a paramount concern for homeowners, businesses, and contractors alike. The presence of hidden environmental hazards can silently compromise both structural integrity and occupant well-being. Proactive identification and professional Asbestos, Mold and Lead Removal [...]
Piedmont Quality Air: Your Expert Partner for Safe Interior Demolition
Piedmont Quality Air: Your Expert Partner for Safe Interior DemolitionTransforming an existing space through renovation or repurposing often begins with a critical first step: interior demolition. This specialized process involves the careful dismantling of internal structures while preserving the building's core integrity and exterior shell. Whether you're a property manager preparing a [...]
Why **Abatement Before Renovation** is Key to a Safe & Successful Project in North & South Carolina
Planning Your Renovation: Why What You Don't See Can Hurt Your Project in North & South CarolinaEmbarking on a renovation project in North or South Carolina is an exciting prospect, but overlooking hidden hazards beneath the surface can transform a dream project into a costly nightmare. Many properties, particularly those built before [...]
Protect Your Investment: Why Expert Building Inspections South Carolina Are Non-Negotiable
Protecting Your South Carolina Property Investment: An OverviewEnsuring the longevity and safety of your property in the Palmetto State is paramount. Comprehensive Building Inspections South Carolina serve as an indispensable tool, offering a proactive approach to identify potential hazards and structural concerns before they escalate into costly problems. From the humid coastal [...]
Seamless Transformations: Piedmont Quality Air’s Expert Commercial Interior Demolition for South Carolina Businesses
Introduction: Seamless Business Transformations for South CarolinaFor South Carolina businesses looking to innovate, expand, or simply refresh their operational spaces, commercial interior demolition offers a vital pathway to seamless transformation. This specialized service is far more nuanced than merely tearing down walls; it's a strategic undertaking that sets the stage for future [...]
Expert Management of Asbestos-Containing Materials (ACM) and Demolition in South Carolina
Understanding Asbestos-Containing Materials (ACM) in South Carolina PropertiesIn South Carolina, many older buildings, particularly those constructed before the 1980s, harbor a silent threat: Asbestos-Containing Materials (ACM). Asbestos, a naturally occurring fibrous mineral, was once widely lauded for its durability, heat resistance, and insulating properties, leading to its prevalent use in a myriad [...]
Expert Asbestos Hazard Management in North Carolina: A Guide by Piedmont Quality Air
Understanding the Hidden Dangers: Asbestos in North Carolina PropertiesFor many property owners and residents, the mention of "asbestos" can evoke immediate concern. This naturally occurring fibrous mineral was once a staple in construction due to its incredible heat resistance, insulating properties, and durability. As a result, countless homes, businesses, and public buildings [...]
Navigate Safe Renovations: Your Guide to the Lead Renovation, Repair and Painting Program with Piedmont Quality Air
Navigating Safe Renovations: Understanding Lead HazardsFor many property owners in South Carolina and North Carolina, the dream of renovation can quickly become a complex challenge, especially when dealing with older structures. Homes built before 1978 often harbor a significant, unseen danger: lead-based paint. When disturbed during renovation, repair, or painting activities, this [...]
Your Guide to Safer Properties: Why Essential Building Inspections South Carolina are Crucial
The Foundation of Safety: Why Proactive Building Inspections are Crucial for South Carolina PropertiesFor property owners, managers, and prospective buyers across the Palmetto State, understanding the critical importance of building inspections is paramount. These assessments are more than a formality; they are a proactive measure to safeguard health, preserve property value, and [...]
Understanding and Preventing Indoor Mold in Your South Carolina Property
The Unseen Threat: Understanding Indoor Mold in South CarolinaIn South Carolina, property owners face a persistent and often invisible enemy: indoor mold. More than just an unsightly stain or a musty smell, mold growth within homes and businesses poses significant health risks and can lead to extensive property damage. Understanding the nature [...]
Expert Interior Commercial Demolition Services for Businesses in NC & SC
Transforming Your Business Space: The Power of Professional Interior Demolition in NC & SCBusinesses across North and South Carolina are constantly evolving, leading to a growing need for adaptable commercial spaces. Whether it's to modernize an outdated layout, repurpose a building for a new tenant, or address structural inefficiencies, interior commercial demolition [...]
Navigating South Carolina Asbestos Regulations Renovations Demolitions 2025: A Critical Guide
Understanding Asbestos in South Carolina: A Silent Threat in Renovations and DemolitionsFor property owners, managers, and contractors across the Palmetto State, navigating South Carolina asbestos regulations renovations demolitions 2025 is a critical safety and legal imperative. Asbestos, a once-valued mineral, now poses severe health risks when its fibers are disturbed, making strict [...]
Piedmont Quality Air: Expert Demolition, Asbestos, Mold and Lead Removal for Safer SC Properties
Protecting Your Investment: Ensuring a Safe and Healthy South Carolina PropertyMaintaining a safe and healthy property in South Carolina requires vigilance, especially concerning hidden environmental hazards. Property owners, managers, and contractors frequently encounter challenges related to demolition, asbestos, mold and lead removal. These elements pose significant health risks and can severely impact [...]
Humidity, Hurricanes & Health: Unpacking Mold Risks In South Carolina
Introduction: South Carolina's Climate and the Looming Threat of MoldSouth Carolina's picturesque landscapes and warm climate, while appealing, unfortunately create an ideal environment for a persistent and often problematic intruder: mold. The unique combination of high humidity, frequent rainfall, and the threat of hurricanes significantly elevates the Mold Risks In South Carolina, [...]
Expert Building Inspections South Carolina: Safeguarding Your Property with Piedmont Quality Air
The Importance of Expert Property Inspections in South CarolinaEnsuring the health and longevity of your property in South Carolina is a critical undertaking for homeowners, property managers, and businesses alike. From the humid coastal regions to the diverse inland landscapes, buildings in the Palmetto State face unique environmental challenges that can compromise [...]
Piedmont Quality Air: Essential Building Inspections South Carolina for a Healthier Property
Understanding Property Health in South CarolinaEnsuring the structural integrity and indoor air quality of properties is paramount for homeowners, property managers, and businesses across the state. In South Carolina's diverse climate, from coastal humidity to inland variations, buildings are susceptible to a range of issues that can compromise their health and the [...]
Ensuring Safe Spaces: The Vital Importance of Post-Demolition Air Quality Testing South Carolina
Beyond the Rubble: Why Demolition Demands a Closer Look at Air QualityDemolition projects, whether for a residential home or a large commercial property in South Carolina, mark a new beginning. Yet, beneath the dust and debris of a demolished structure, unseen dangers can linger, significantly impacting indoor air quality. Ensuring a truly [...]
South Carolina Storm Recovery: Asbestos Removal & Safety for Homeowners & Businesses after a Severe Weather Event
Introduction: When South Carolina Storms Hit HomeSouth Carolina is no stranger to severe weather events, from hurricanes lashing the coast to intense thunderstorms sweeping inland. While the immediate aftermath often focuses on visible damage, a silent and significant threat can emerge: disturbed asbestos-containing materials (ACMs). For homeowners and businesses across the Palmetto [...]
South Carolina Asbestos Removal Regulations 2025: Your Essential Guide to Compliance and Safety
Navigating Asbestos: Your South Carolina Compliance and Safety GuideEnsuring the safety of your property and its occupants requires a thorough understanding of hazardous materials, particularly asbestos. As a homeowner, property manager, or contractor in the Palmetto State, staying informed about South Carolina asbestos removal regulations 2025 is not just a recommendation, it's [...]
Expert Strategies to Prevent Indoor Mold in South Carolina Homes for a Healthier Home
The Silent Invader: Why Mold Prevention Matters in South Carolina HomesSouth Carolina, with its beautiful coastlines and lush landscapes, unfortunately, also offers an ideal environment for a hidden menace: indoor mold. The prevalence of high humidity, especially during warmer months, makes it crucial for homeowners and property managers to actively prevent indoor [...]
Hazardous Materials & Structural Issues: The Case for Full-Scale Demolition Over Renovation in SC & NC
The Renovation vs. Demolition Dilemma: When Hazardous Materials & Structural Issues Demand MoreProperty owners, developers, and businesses in South Carolina and North Carolina often face a pivotal decision: renovate an existing structure or opt for a complete overhaul through full-scale demolition over renovation. While renovation offers the allure of preserving character and [...]
Stay Compliant in SC: Understanding SC DES asbestos requirements 2025 with Piedmont Quality Air
Introduction: Navigating Asbestos Regulations in South CarolinaFor property owners, managers, and contractors in the Palmetto State, understanding SC DES asbestos requirements 2025 is not just good practice—it's a critical legal and safety imperative. Asbestos, a naturally occurring mineral once lauded for its fire-resistant and insulating properties, poses severe health risks when disturbed, [...]
Decoding the Dangers of Indoor Mold in South Carolina: What Every Property Owner Needs to Know
Understanding Indoor Mold in South Carolina: An Introduction Indoor mold is a pervasive concern for property owners across South Carolina. More than just an unsightly nuisance, the presence of mold within homes and businesses can pose significant health risks and lead to considerable property damage. Understanding what mold is, why it thrives [...]
Demolition in SC: Your Complete Guide to South Carolina demolition notification and permit requirements
Starting Your Demolition Project in South Carolina: The Importance of ComplianceUndertaking a demolition project in South Carolina is a significant undertaking, whether it's for a residential property or a commercial structure. Beyond the physical aspects of tearing down a building, there's a critical layer of regulatory adherence that property owners, managers, and [...]
Essential Guide: South Carolina demolition notification and permit requirements for Safe & Compliant Projects
Introduction: Why Demolition Compliance Matters in South CarolinaUndertaking a demolition project in South Carolina, whether for a residential home or a commercial building, is a significant endeavor that demands meticulous planning and strict adherence to regulations. Navigating the landscape of South Carolina demolition notification and permit requirements is not merely a bureaucratic [...]
Navigating SCDES asbestos demolition regulations South Carolina: A Comprehensive Guide for Safe Compliance
The Imperative of Safe Asbestos Demolition in South CarolinaDemolition and renovation projects are complex undertakings, and in South Carolina, they carry a significant responsibility: ensuring the safe handling of asbestos. Asbestos, once a ubiquitous building material due to its heat resistance and durability, is now recognized as a severe health hazard. Disturbing [...]
Your Guide to Understanding N.C. Asbestos Rules, Regulations & Ordinances with Piedmont Quality Air
Introduction to Asbestos Regulations in North CarolinaUnderstanding the complex landscape of N.C. Asbestos Rules, Regulations & Ordinances is crucial for homeowners, property managers, and contractors alike. Asbestos, a naturally occurring mineral fiber, was widely used in construction due to its heat resistance and insulating properties. However, its microscopic fibers can become airborne [...]
Post-Flood: Asbestos Mold Remediation South Carolina Floods
Understanding Post-Flood Environmental Risks in South Carolina South Carolina is no stranger to severe weather events, and while the immediate aftermath of floods and hurricanes brings visible devastation, it's the hidden dangers that often pose the most significant long-term threats to health and property. Among these invisible hazards are asbestos and mold, [...]
Crawl Space Mold Removal SC: Protect Your SC Home Now
Crawl spaces are often out of sight, out of mind, but for homes in South Carolina, this neglected area can become a breeding ground for mold. The humid climate of the Palmetto State, combined with common issues like poor ventilation and moisture intrusion, creates the perfect environment for mold to thrive. If [...]
Evaluating SCDES Impact on SC Hazardous Removal Efficiency
Understanding South Carolina's Environmental Protection Framework South Carolina's commitment to environmental health and safety is anchored by its dedicated regulatory body, the South Carolina Department of Environmental Services (SCDES). This agency plays a pivotal role in safeguarding the state's natural resources and public well-being by establishing and enforcing environmental regulations. For homeowners, [...]
Expert Post-Hurricane Asbestos Mold Remediation SC Services
Hidden Hazards After the Storm Identifying Risks to Your Property After a severe weather event, such as a hurricane or significant flood, the immediate dangers might seem to subside once the winds die down and waters recede. However, for homeowners, property managers, and businesses across South Carolina, a new set of critical [...]
Protect Your Home: Professional Mold Inspection South Carolina
Understanding Mold Growth in South Carolina Homes Mold is a persistent challenge for homeowners, property managers, and businesses, particularly in areas known for their warm, humid climates. South Carolina, with its coastal regions, frequent rainfall, and hot summers, provides an ideal environment for mold spores to thrive. These microscopic organisms require moisture, [...]
North Carolina Asbestos Storm Damage Cleanup: Your Guide
Understanding Asbestos Hazards After Severe Weather Severe weather events, from hurricanes to strong thunderstorms, can wreak havoc on homes and businesses across North Carolina. Beyond the immediate damage, property owners face a hidden danger: disturbed asbestos. When buildings are impacted by high winds, heavy rain, or flooding, materials containing asbestos can be [...]
Ensuring Safety: Mold Remediation South Carolina Hospitals
The Silent Invader: Why Mold is a Critical Concern in Hospitals In healthcare environments, maintaining impeccable indoor air quality is not just a preference; it's a critical component of patient safety and staff well-being. Hospitals are unique ecosystems where vulnerable individuals are especially susceptible to environmental contaminants. Among these, mold poses a [...]
Your Path to South Carolina Mold Remediator Certification
Addressing Mold in South Carolina: The Need for Professional Standards Mold growth is a persistent issue for homeowners and businesses alike, particularly in humid climates like that of South Carolina. Beyond the visible unsightly stains, mold can significantly impact indoor air quality and, in some cases, pose health risks. When mold infestations [...]
Safe Storm Damage Asbestos Removal South Carolina
Severe weather events, common occurrences in South Carolina, can unfortunately leave behind more than just visible destruction. Flooding, high winds, and structural damage can expose hidden hazards within buildings, one of the most serious being asbestos. When materials containing asbestos are disturbed by storm damage or subsequent cleanup and repair efforts, microscopic [...]
Commercial mold remediation South Carolina: Why Act Fast
Mold is a common issue, and in the humid climate of South Carolina, it can pose a significant threat to commercial properties. Beyond an unpleasant smell or unsightly patches, mold growth can lead to serious health concerns for employees and customers, as well as substantial structural damage to the building itself. Addressing [...]
Successfully Restoring SC Home Value After Mold
Understanding How Mold Impacts Your Home's Worth Discovering mold in your South Carolina home can be a distressing experience, not only for the potential health risks it poses but also for its significant impact on your property's market value. For many homeowners, their house is one of their most valuable assets. Protecting [...]
SC renters lack legal mold protection: What to do
Understanding the Mold Problem in South Carolina Rentals Mold is a pervasive issue that affects properties across the United States, and South Carolina is particularly susceptible due to its warm, humid climate and vulnerability to flooding events. For many residents, especially those living in rental properties, discovering mold can trigger significant concern. [...]
Understanding South Carolina Asbestos Removal Laws
The Hidden Dangers of Asbestos in South Carolina Asbestos is a naturally occurring fibrous mineral that was once widely used in construction and manufacturing due to its exceptional heat resistance, tensile strength, and insulating properties. From the early 20th century through the late 1970s, it was incorporated into a vast array of [...]
Removing hazardous materials before demolition SC: Safety First
Why Hazardous Material Removal is Essential Before Demolition Embarking on a demolition project, whether for a residential renovation or a large-scale commercial teardown, is a significant undertaking. While the visible aspects like heavy machinery and structural dismantling are often the focus, what lies hidden within the building materials themselves is arguably the [...]